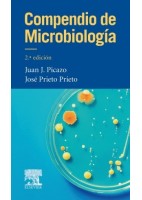
COMPENDIO DE MICROBIOLOGIA

Lista de productos por editorial ELSEVIER
PATOLOGIA MEDICO-QUIRURGICA PARA FISIOTERAPEUTAS. GENETICA, NEUROLOGIA,... + info
62,09 €-5% 65,36 €PATOLOGIA MEDICO-QUIRURGICA PARA FISIOTERAPEUTAS. GENETICA, NEUROLOGIA, NEUMOLOGIA, CARDIOLOGIA, PATOLOGIA VASCULAR, HEMATOLOGIA Y ONCOLOGIA
¡Oferta!INVESTIGACION EN METODOLOGIA Y LENGUAJES ENFERMEROS + info
47,40 €-5% 49,90 €INVESTIGACION EN METODOLOGIA Y LENGUAJES ENFERMEROS
¡Oferta!NELSON. TRATADO DE PEDIATRIA + EXPERT CONSULT + info
220,81 €-5% 232,43 €NELSON. TRATADO DE PEDIATRIA + EXPERT CONSULT
¡Oferta!SINDROME DEL INTESTINO IRRITABLE (CLINICAS IBEROAMERICANAS DE... + info
55,41 €-5% 58,33 €SINDROME DEL INTESTINO IRRITABLE (CLINICAS IBEROAMERICANAS DE GASTROENTEREOLOGIA Y HEPATOLOGIA VOL.8)
¡Oferta!PEDIATRICS IN SYSTEMIC AUTOIMMUNE DISEASES + info
105,72 €-5% 111,28 €PEDIATRICS IN SYSTEMIC AUTOIMMUNE DISEASES
¡Oferta!CLINICAL CARDIAC PACING, DEFIBRILLATION AND RESYNCHRONIZATION THERAPY (ONLINE... + info
225,25 €-5% 237,11 €CLINICAL CARDIAC PACING, DEFIBRILLATION AND RESYNCHRONIZATION THERAPY (ONLINE AND PRINT)
¡Oferta!MANUAL DE TRATAMIENTO DE SOPORTE EN EL PACIENTE ONCOLOGICO BASADO EN LA EVIDENCIA
¡Oferta!ENFERMERIA CLINICA I: CUIDADOS GENERALES Y ESPECIALIDADES MEDICOQUIRURGICAS + info
44,32 €-5% 46,65 €ENFERMERIA CLINICA I: CUIDADOS GENERALES Y ESPECIALIDADES MEDICOQUIRURGICAS
¡Oferta!BASES ANATOMICAS DEL DIAGNOSTICO POR IMAGEN + info
109,85 €-5% 115,63 €BASES ANATOMICAS DEL DIAGNOSTICO POR IMAGEN
¡Oferta!MEDICAL PHYSIOLOGY + info
89,92 €-5% 94,65 €MEDICAL PHYSIOLOGY
¡Oferta!ATLAS OF ABDOMINAL WALL RECONSTRUCTION + info
187,72 €-5% 197,60 €ATLAS OF ABDOMINAL WALL RECONSTRUCTION
¡Oferta!ELEMENTOS DE RADIOFISICA PARA TECNICOS SUPERIORES EN RADIOTERAPIA Y DOSIMETRIA + info
44,32 €-5% 46,65 €ELEMENTOS DE RADIOFISICA PARA TECNICOS SUPERIORES EN RADIOTERAPIA Y DOSIMETRIA
¡Oferta!INVESTIGACION EN ENFERMERIA + info
51,20 €-5% 53,90 €INVESTIGACION EN ENFERMERIA
¡Oferta!BIENESTAR ANIMAL + info
66,54 €-5% 70,04 €BIENESTAR ANIMAL
¡Oferta!COMPLICACIONES EN LA CIRUGIA DEL CRISTALINO + info
177,60 €-5% 186,95 €COMPLICACIONES EN LA CIRUGIA DEL CRISTALINO
¡Oferta!DEFORMACIONES MORFOLOGICAS DE LA COLUMNA VERTEBRAL. TRATAMIENTO... + info
44,32 €-5% 46,65 €DEFORMACIONES MORFOLOGICAS DE LA COLUMNA VERTEBRAL. TRATAMIENTO FISIOTERAPEUTICO EN REEDUCACION POSTURAL GLOBAL RPG
¡Oferta!KANSKI OFTALMOLOGIA CLINICA. UN ENFOQUE SISTEMATICO + info
125,25 €-5% 131,84 €KANSKI OFTALMOLOGIA CLINICA. UN ENFOQUE SISTEMATICO
¡Oferta!ESTRATEGIAS DIAGNOSTICAS EN PEDIATRIA + info
49,87 €-5% 52,49 €ESTRATEGIAS DIAGNOSTICAS EN PEDIATRIA
¡Oferta!ENFERMERIA EN NEURORREHABILITACION + info
44,32 €-5% 46,65 €ENFERMERIA EN NEURORREHABILITACION
¡Oferta!HEPATITIS VIRICAS (CLINICAS IBEROAMERICANAS DE GASTROENTEROLOGIA Y HEPATOLOGIA VOL. 7)
¡Oferta!GUIA MOSBY DE TECNICAS Y PROCEDIMIENTOS EN ENFERMERIA + info
44,56 €-5% 46,90 €GUIA MOSBY DE TECNICAS Y PROCEDIMIENTOS EN ENFERMERIA
¡Oferta!COMPENDIO DE MICROBIOLOGIA + info
44,32 €-5% 46,65 €COMPENDIO DE MICROBIOLOGIA
¡Oferta!TRAUMATISMOS DEL POLO POSTERIOR + info
35,54 €-5% 37,41 €TRAUMATISMOS DEL POLO POSTERIOR
¡Oferta!INNOVACIONES TERAPEUTICAS EN ENDOSCOPIA DIGESTIVA (CLINICAS IBEROAMERICANAS DE GASTROENTEROLOGIA Y HEPATOLOGIA, VOL. 6)
¡Oferta!
Novedades
-

-

-

MINITORNILLOS. APLICACION DE MINITORNILLOS EN ORTODONCIA
MINITORNILLOS. APLICACION DE MINITORNILLOS EN ORTODONCIA
180,00 € -

-

-

-

-

FIRESTEIN Y KELLEY TRATADO DE REUMATOLOGIA (2 VOL.)
FIRESTEIN Y KELLEY TRATADO DE REUMATOLOGIA (2 VOL.)
380,00 €
LibreriaMedica.es
 Conócenos
Conócenos Estudiantes
 Estudiantes
Estudiantes